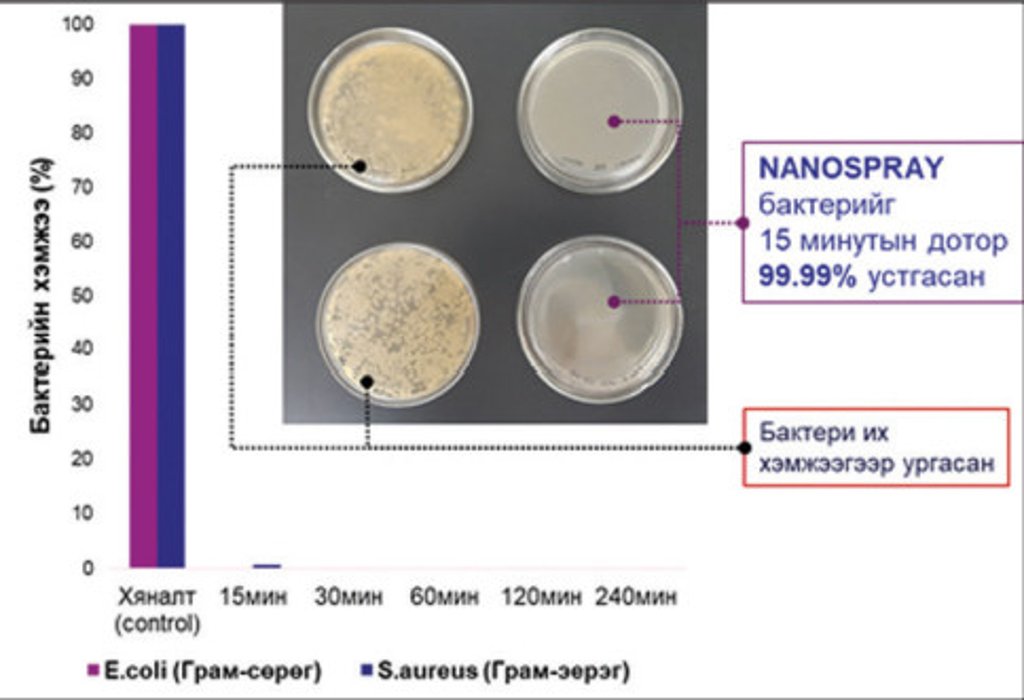

“Багш, оюутны старт-ап 2020” хөтөлбөрт оролцон “Зэс-цайрын ислийн композит нанопартикл агуулсан бактерийн эсрэг цацлага үйлдвэрлэх” төслөөрөө тэргүүлж 12 сая төгрөгийн тэтгэлэг авсан ХШУИС, ХБИТ-ийн дэд проф. Х.Тэгшжаргал удирдагчтай “NSIA” багийн судалгааны ажлыг танилцуулж байна.

“NSIA” багийн бүтээгдэхүүн нь “Coppart” гэж нэрлэгдсэн бактерийн эсрэг үйлчилгээтэй цацлага юм. Уг санааг багийн гишүүн магистрант Ц.Номин гаргаж, багийн бусад гишүүдийн оролцоотойгоор үргэлжлүүлэн хөгжүүлэлт, судалгааг хийж байна.
COVID-19 вирусийн тархалттай холбоотойгоор сүүлийн нэг жил хагасын хугацаанд хүн төрөлхтөн биологийн жижиг биет болох вирус, бактериудын тухай гүнзгий ойлголттой болсон. Манай улсад ч вирус, бактерийн тархалтын эсрэг өдөр тутмын ариутгалын асуудалд санаа тавьж эхлэв.
Зах зээл, худалдаанд байдаг ихэнх ариутгалын бодисууд хими болон биологийн гаралтай байдаг боловч устгах чадвар нь 99.99 хувь байдаг. Хэдийгээр 0.01 хувиас бусад бактерийг үхүүлж байгаа гэж ойлгогдох боловч энэ тоо нь бактерийн хувьд дахин олшрох боломжтой хангалттай их тоо юм. Энэхүү амьд үлдсэн 0.01 хувь нь цаашид өсч үржих бөгөөд энэ үед бактерийн мутаци үүсч бидний хэрэглээд байгаа ариутгалын бодист тэсвэртэй болох магадлалтай.
Хэдхэн жилийн өмнөөс хүн төрөлхтөн антибиотикт тэсвэртэй бактериудтай нүүр тулж эхэлсэн буюу шинээр зохиогдож байгаа бактерийн эсрэг үйлчилгээтэй бодис болох антибиотикийг зохиох хурд нь шинэ бактерийн мутаци үүсэх хурдад гүйцэгдсэн. “NSIA” баг уг асуудлыг шийдэхийн тулд бактерийн эсрэг үйлчилгээтэй нано зэс агуулсан бүтээгдэхүүнийг судалж, бий болгохоор ажилласан бөгөөд олон сарын турш хэд хэдэн туршилт хийсний үр дүнд бактерийн эсрэг үйлчилгээтэй нэгдэл гаргаж авч чадсан.

Тус багийн бүтээгдэхүүний давуу тал нь хатуу гадаргуу дээр нимгэн бүрхүүл үүсгэн тухайн гадаргуутай харилцан үйлчилсэн бактериудыг 99.99% устгаж, дахин үржих боломжийг зогсоох үйлчилгээтэй байгааг эхний туршилтын үр дүнгүүд харуулав. Мөн зэсийн нано материал сонгож авсан шалтгаан бол мөнгө, титан зэрэг бусад бактерийн эсрэг үйлчилгээтэй наноматериалуудтай харьцуулахад зэс нь илүү хямд мөн хор багатай байдаг бөгөөд дэлхийн олон эрдэмтний судалгаанууд зэсийн нэгдлүүд бактерийн эсрэг төдийгүй COVID-19 вирусийн эсрэг үйлчилгээтэй байгааг харуулсан.
Худалдаанд байдаг ариутгалын бодисууд зөвхөн тухайн цэвэрлэх агшинд л бактерийг устгаад дуусдаг бол “Coppart” нь удаан хугацаанд бактерийг устган гадаргуу дээрээ байсаар байдаг давуу талтай. Олон улсын зах зээлд “Coppart”-тэй ижил төстэй бүтээгдэхүүнүүд худалдаалагдаж эхэлсэн боловч нэгж бүтээгдэхүүний үнэ маш өндөр байгааг доорх зургаас харж болно.

Эх сурвалж: МУИС-ийн мэдээ

Та энэ хүслийг өөр дээрээ нэмсэн байна!

Та энэ хүслийг биелүүлсэн байна!